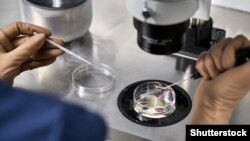

Сообщество выпускников биологического факультета МГУ распространило в Facebook'е пост, в котором потребовало от ряда российских прокремлевских СМИ прекратить «лживую пропаганду, основанную на дезинформации и ненависти». Речь идет о публикациях СМИ, в которых утверждается, что в Украине якобы шла разработка биологического оружия.
6 марта Минобороны России опубликовало документы, в которых говорится, что в Украине якобы создавалось биологическое оружие. Официальный представитель ведомства генерал-майор Игорь Конашенков заявил, что 24 февраля в полтавских и харьковских лабораториях были экстренно уничтожены возбудители чумы, сибирской язвы, туляремии, холеры и других смертельных болезней.
После этого в проправительственных СМИ появились десятки сообщений, в которых утверждалось, что якобы украинские биолаборатории выполняли заказы Пентагона. 9 марта пресс-секретарь президента России Дмитрий Песков заявил, что «наверняка всему миру будет интересно понять и узнать, чем занимались эти учреждения».
10 марта начальник войск радиационной, химической и биологической защиты (РХБЗ) ВС РФ Игорь Кириллов сообщил, что биолаборатории во Львове работали с возбудителями чумы, сибирской язвы и бруцеллеза, в Харькове и Полтаве — с возбудителями дифтерии, сальмонеллеза и дизентерии.
В Украине и США эти сообщения назвали дезинформацией и заявили, что страны сотрудничают исключительно в областях создания вакцин и обнаружения вспышек заболеваний, вызванных опасными патогенами.
В ответ сообщество выпускников биофака МГУ распространило в Facebook'е пост, который анализирует обвинения представителей российского Минобороны. Его автор Евгений Левитин, кандидат биологических наук, микробиолог, генный инженер и молекулярный биолог, рассказал «Сибирь.Реалиям», проекту Русской редакции Азаттыка, почему он потребовал опровергнуть заявления, сделанные российскими официальными лицами.
«Сибирь.Реалии»: Почему вы написали открытое письмо в редакции РИА «Новости», «Газета.ру», Russia Today, «Фонтанки», «Комсомольской правды» и других СМИ, опубликовавших сообщения о том, что Украина якобы экстренно устранила следы программы по созданию биологического оружия, которая финансировалась Пентагоном?
Евгений Левитин: Потому что они написали чистую ложь. Это сознательная ложь, которая никак и ничем не оправдана. Это станет очевидно для любого человека, который даст себе труд просто внимательно прочесть документы, приложенные к утверждению о создании в Украине биологического оружия.
Объясню на простом примере. Представьте: вы приходите в некий офис и видите на одной из комнат надпись: «Инструкция для уборщицы. Два раза в день производить влажную уборку помещения». Из этого вы делаете вывод, что в этой комнате украинские националисты два раза в день живьем расчленяют людей и приносят их в жертву Ктулху, а потом замывают следы. Заявление официального представителя Минобороны РФ Игоря Конашенкова в комбинации с приложенными к этому заявлению документами производит именно такое впечатление.
«Сибирь.Реалии»: Но почему? В документах о ликвидации опасных патогенов в украинских лабораториях есть длинный список возбудителей болезней…
Евгений Левитин: Сравните его со списком так называемых особо опасных инфекций. В опубликованном списке препаратов, утилизированных в полтавских и харьковских лабораториях, ничего подобного нет. Давайте разберемся, какие патогены в нем перечислены.
Corynebacterium diphtheriae — это потенциально опасный, но совершенно непригодный для широкого распространения штамм возбудителя дифтерии. Очень трудно заразиться дифтерией, пока вам в горло не вольют полную ложку этой культуры — вот тогда вам будет плохо.
Corynebacterium pseudodiphteriticum — это бактерии, которые являются частью нормальной микрофлоры верхних дыхательных путей и кожи человека. Это уже чисто условный патоген. Он может нанести вред здоровью человека только в условиях иммунного дефицита.
Corynebacterium xerosis — это то, что потенциально у некоторых людей может вызвать воспаление слизистых. Вещь, конечно, довольно неприятная, но лечится специальным кремом.
Baсillus lihenifprmus «С» — это штамм, с которым вы имеете дело постоянно. Он встречается где угодно, даже во вчерашнем борще.
Baсillus stearothermophilis, может, считается условным патогеном, но, опять-таки, этой бациллы нужно проглотить очень много, и даже у человека с иммунодефицитом она не вызовет опасных заболеваний.
Staphilococcus aureus — тоже самая обычная вещь, заразиться которой можно просто из воздуха. Если вы чашку на столе оставите, то каждая сотая колония бактерий, которая там образуется, — это золотистый стафилококк. Да, бывает, что из-за него на горле человека вырастают желтые блямбы, но это не стафилококк виноват, а состояние организма.
Escherichia coli — у нас у всех в кишечнике есть эта кишечная палочка. Если высевать образцы микрофлоры, то у половины людей будет встречаться эта Escherichia coli. Это не очень хорошо, поскольку означает, что мы плохо питаемся и нужно внести изменения в систему питания, но это не означает, что это опасная зараза.
Pseudomonas aeruginosa — это синегнойная палочка, обитающая в воде и почве, она условно патогенна для человека. Klebsiella pneumoniae тоже условный патоген.
Всё, что перечислено в опубликованных документах, — это условные патогены, за исключением Clostridium diphtheriae. Но и этот возбудитель не относится к группе особо опасных патогенов.
«Сибирь.Реалии»: Тогда зачем в украинских лабораториях хранились эти штаммы?
Евгений Левитин: Они используются в любом эпидемиологическом институте, в любой микробиологической лаборатории, даже в любой санэпидемстанции, где высевают пробы. Эти штаммы нужны для сравнения. Вот приходит человек, сдает мазок из горла, специалисты делают посев и смотрят, что же нехорошее у него там развивается. Выращенные на чашке штаммы нужно с чем-то сравнивать. Поэтому образцы есть в любой нормальной лаборатории, которая занимается эпидемиологией или даже просто микробиологией.
Для того чтобы хранить такие штаммы, не нужно даже специального разрешения. Эти патогены не являются предметом специально регистрируемого хранения. Нужно лишь заполнять особую форму, подтверждающую, что они есть. Это обычная практика.
«Сибирь.Реалии»: Если это самые обычные штаммы, которые широко используются, зачем же тогда украинские биолаборатории экстренно уничтожили их 24 феврали, как заявил Конашенков?
Евгений Левитин: Потому что это тоже обычная практика. Периодически — каждые полгода, например, — в эпидемиологическом институте проходит учет, и часть культур, не нужных для дальнейшей работы, утилизируют. То есть аккуратно уничтожают различными способами обеззараживания. Причем так утилизируют даже самые невинные штаммы, ведь не выкидывать же их на помойку.
Здесь та же самая ситуация. Эпидемиологические лаборатории, у которых даже нет разрешения работать с особо опасными инфекциями, утилизировали культуры потенциально вредных бактерий. Они выполнили приказ Министерства здравоохранения Украины от 24 февраля 2022 года об утилизации возбудителей в условиях чрезвычайного положения. Цель — предотвратить разного рода случайности, которые могли бы привести к попаданию биокультур во внешнюю среду. Это разумное решение.
«Сибирь.Реалии»: Получается, что уничтожены были штаммы, которые не являются особо опасными. Почему же тогда генерал Конашенков заявил об уничтожении возбудителей чумы, сибирской язвы, туляремии, холеры и других смертельных болезней?
Евгений Левитин: Это совершенное вранье в его чистейшем виде. Чума, сибирская язва, туляремия, холера — всего этого в опубликованных документах нет. Расчет просто на то, что люди не читают ни по-украински, ни на латыни и не знают названий патогенов.
Так работает пропаганда. Минобороны сделало ложное, ни на чем не основанное заявление — и теперь, если я пообщаюсь с людьми, то 90 процентов из них скажут: «На Украине делали биологическое оружие». Никто приложенных документов и не прочел. А те, что прочли, скажут: «Ну да, может, именно в этих документах никаких опасных возбудителей и нет. Но нам ведь не зря об этом говорят. Может, в других документах, которые нельзя публиковать открыто, опасные штаммы есть». Такой вариант реакции тоже возможен.
Всё это пропаганда в ее чистом, дистиллированном виде. Ложь без какого-либо основания.
«Сибирь.Реалии»: Может ли случиться, что Минобороны России позже действительно обнаружит в украинских биолабораториях возбудителей чумы, сибирской язвы или холеры?
Евгений Левитин: Конечно, в Украине наверняка есть лаборатории, которые работают и с особо опасными патогенами. И это тоже нормально. Сотни лабораторий в России имеют официальное разрешение на работу с сибирской язвой, например.
Я работал во Франции в лаборатории, которая занималась зоопатологией и изучала паразитов домашних животных. И эта обычная ветеринарная лаборатория тоже имела разрешение на работу с особо опасными инфекциями. Чтобы его получить, лаборатория просто должна быть правильно оборудована и правильно регистрировать опасные штаммы. Если специалисты с ними работают, это не означает, что они разрабатывают биологическое оружие.
Если Минобороны РФ обнаружит в Украине документы лабораторий, которые имеют официальное разрешение на работу с опасными штаммами, в этом тоже не будет ничего удивительного и страшного. Но военное ведомство не потрудилось дождаться даже такого повода для пропаганды. Возможно, у них не было на это времени.
Как мне кажется, заявление о разработке биологического оружия в Украине было заготовлено и согласовано заранее. Ведь сразу же после заявления Минобороны РФ выступил официальный представитель МИД Китая Чжао Лизцянь, который призвал США прояснить свою деятельность по биологической милитаризации. Китайский представитель постарался раздуть панику, заявив, что в Украине работают американские биолаборатории, на которые США тратит сотни миллионов долларов, и эти лаборатории явно занимаются чем-то не тем.
«Сибирь.Реалии»: Может ли оказаться, что в Украине действительно есть лаборатории, которые получают финансирование из США?
Евгений Левитин: Конечно. Потому что и это тоже нормальная практика. Стоимость труда в Украине гораздо меньше, чем в Америке. И если какой-то американской компании нужно получить определенный белок, чтобы провести иммунизацию или нарастить биомассу, чтобы исследовать влияние некого вещества на микробов, то в десятки раз дешевле сделать это в Украине, чем в Америке. Поэтому американцы наверняка используют этот аутсорсинг.
Точно так же американские фирмы отдают часть работ на аутсорсинг в Китай, во Вьетнам или в Индию. В России такое тоже было распространено, пока в нашей стране не начали душить международное сотрудничество.
Лаборатории, выполняющие заказы для иностранных фирм, могут быть самого разного типа, не только биологические, но и химические, и геологические. Наука — она вообще общемировая, она не привязана к какой-то одной стране. Если биолаборатория в Украине работает на деньги из США, это не означает, что она разрабатывает биологическое оружие.
К тому же вряд ли в Украине есть лаборатории, которые полностью работают не на частные фирмы, а на такие государственные структуры США, как National Institutes of Health. Украина слишком долго была бедной страной, и там осталось мало специалистов, которые могли бы выполнять настолько серьезные заказы, как разработка биологического оружия. Большая часть из них, к сожалению, уже уехала. Хороший специалист предпочтет работать в Америке за доллары, а не в Украине за гривны. Собственно, и в России такая же ситуация.
«Сибирь.Реалии»: Во многих российских СМИ муссируется тема, что власти США разрабатывали в украинских лабораториях не просто биологическое оружие, а оружие именно против славян. Что они изучали славянскую ДНК…
Евгений Левитин: Заявление о «славянской ДНК» — это просто бред для любого, кто помнит школьный курс биологии. Такие заявления восходят к теориям немецких национал-социалистов с их культом «арийской высшей расы». Дело в том, что народов как генетических общностей вообще не существует. Это общее место для всех биологов уже примерно 150 лет. И такого народа, как славяне, тоже нет.
Славянские языки начали очень стремительно распространяться в 5–6 веках н. э. Предки современных болгар пошли на юг и завоевали фракийское население. Предки современных русских пошли на север и завоевали территории, населенные финно-угорскими народами. Западные славяне ассимилировали кельтское население, жившее в Европе. Местное население не изменилось генетически, оно просто усвоило язык и культуру пришельцев. В процессе ассимиляции произошло смешение кровей. И это только один этап, а ведь было еще великое переселение народов, татаро-монгольское завоевание и т. д, и т. п.
Чтобы убедиться, насколько масштабным было смешение кровей, достаточно изучить генетическую карту мира. Доля славянских генов есть не только у финнов или поляков, но и у китайцев. А такой генетической общности, как славяне, а тем более русские или украинцы — ее просто нет. Ее невозможно даже как-то обозначить. Русские и украинцы — как два салата, сделанные из одних и тех же компонентов. В одном больше одних компонентов, а в другом — других. Более того, у жителей Ростова-на-Дону и Харькова будет больше общего, чем у уроженца карельской деревни и сибиряка.
Все народы — это месиво из самых различных генов. И никакой особой ДНК славян нет.
Изучать славянскую ДНК, чтобы создать биологическое оружие против славян — это тоже полный бред. Даже если бы удалось разработать такое биооружие — а в ближайшем будущем это невозможно, — его не удалось бы успешно применить. Любой, кто захотел бы убить с его помощью треть русских, уничтожил бы и как минимум четверть населения своей страны.
«Сибирь.Реалии»: Если взять максимально отдаленные территориально народы — например, жителей Центральной Африки и Китая, — можно ли создать биологическое оружие, которое будет опасно для одной нации и ничем не будет угрожать другой?
Евгений Левитин: Хорошо, давайте представим, что, допустим, африканское племя зулу вдруг создало биологическое оружие против всего остального мира. Чисто теоретически такое возможно. Например, в Африке распространен генотип, который подвержен серповидоклеточной анемии. Очень неприятная вещь. У людей с таким генотипом при любом недостаточном снабжении кислородом, при сердечной недостаточности эритроциты съеживаются и с трудом переносят кислород. Этот генотип распространен в Африке, поскольку он защищает от малярии. И вот зулу взяли и попытались заразить малярией китайцев. Да, погибших среди зулу будет примерно вполовину меньше, чем в остальном мире, но потери всё равно будут с двух сторон. Так зачем нужно такое оружие, если обычное работает гораздо эффективнее?
Давайте даже представим ситуацию с куда более смертельной болезнью, чем малярия. Допустим, зулу решили сбросить на весь мир микробиологические бомбы с огромным количеством бациллы сибирской язвы. Как самим зулу избежать смерти? Самый простой способ — вакцинировать заранее свое население. Но, во-первых, вероятность заражения всё равно остается. А во-вторых, в современном мире с методами ПЦР невозможно сохранить использование этого оружия в тайне. Возбудителя очень легко идентифицировать. Реальное применение биологического оружия невозможно в силу своей неэффективности и легкого обнаружения. Оно серьезно проигрывает по сравнению с обычным оружием.
«Сибирь.Реалии»: Какие доказательства должно было привести Минобороны России, чтобы убедить весь мир в том, что в Украине действительно разрабатывалось биологическое оружие? Можно ли, к примеру, взять возбудителей чумы или сибирской язвы из российских лабораторий и заявить, что они обнаружены в Украине?
Евгений Левитин: Это очень рискованно для своей же репутации. Например, выяснится, что этот штамм чумы уже описан в российской лаборатории. Минобороны РФ предъявит международным экспертам возбудителя, а они ответят: «Простите, но это штамм из Монголии. Что вы нам лапшу вешаете». Ведь все штаммы так же индивидуальны, как отпечатки пальцев.
Можно, конечно, отыскать какой-то штамм, который широко распространен и используется в сотнях мировых лабораторий. Но, как мы уже говорили, то, что он будет представлен как найденный в Украине, не станет доказательством разработки биологического оружия. Нужно будет предъявить мировому сообществу… (смеется) некий найденный в Украине бак, в котором содержатся десятки килограммов спор сибирской язвы. Только тогда это будет подозрительно. Это такая же ситуация, как если бы Минобороны РФ заявило, что Украина готовилась нанести по России ядерный удар. Тогда нужно было бы продемонстрировать тысячи килограммов оружейного плутония, якобы изготовленного на украинских предприятиях.
Но в обоих случаях подделку было бы легко разоблачить. Хорошую фальшивку вообще очень трудно сделать. Когда человек делает какую-то работу, то ему проще сделать эту работу, чем сфабриковать фальшивку о том, что она действительно проведена. Это то же самое, что попытаться сымитировать чужое письмо, причем на чужом языке и из другой эпохи. Я могу сейчас попробовать написать послание от имени человека 20-х годов прошлого века, но любой мало-мальски грамотный специалист тут же обнаружит, что это липа. Обнаружить подделку гораздо легче, чем ее изготовить.
Судя по абсурдности уже прозвучавших обвинений, Минобороны РФ вообще не очень озабочено тем, чтобы приводить достоверные доказательства. Достаточно заявить, что Украина разрабатывает биологическое оружие, и опубликовать первые попавшиеся документы. А потом, если поднимется шум, заявить: «Простите, мы сделали необдуманное заявление».
«Сибирь.Реалии»: Осадок всё равно останется, пропаганда сработает?
Евгений Левитин: На это и расчет. Возможно, Минобороны РФ и хотело найти нечто более убедительное, чем опубликованные документы об утилизации условно опасных штаммов. Но, честно говоря, я не думаю, что они вообще сейчас об этом думали. Ведь обвинение в создании биологического оружия нужно срочно, прямо сейчас. Не через полгода и не для международного сообщества. Оно рассчитано на моментальный эффект среди россиян. А все иностранные специалисты, которые это заявление видят, просто диву даются.
Мой пост с обращением к редакциям пропагандистских СМИ прочитали многие, в том числе и довольно известные ученые. Они оценили достоверность доказательств и сказали, что это просто какое-то безумие. А на мое предложение как-то распространить эту информацию ответили: «А стоит ли? Если к этой очевидной лжи отнестись слишком всерьез, могут подумать, что, может, там что-то и в самом деле есть… А так это просто очевидный абсурд».
Возможно, они правы для своей среды. Но здесь, в России, ситуация другая. Здесь 90 процентов людей поверило в очевидно ложные обвинения.
«Сибирь.Реалии»: Вы рассчитывали на ответ от редакций СМИ, которые опубликовали эту ложь?
Евгений Левитин: Честно, говоря, нет, не рассчитывал. Если они написали это, то ничего другого писать уже не будут. Очень жаль, что в России теперь можно публиковать такие абсурдные фальшивки. В другие времена невозможно было представить ничего подобного.

КОММЕНТАРИИ